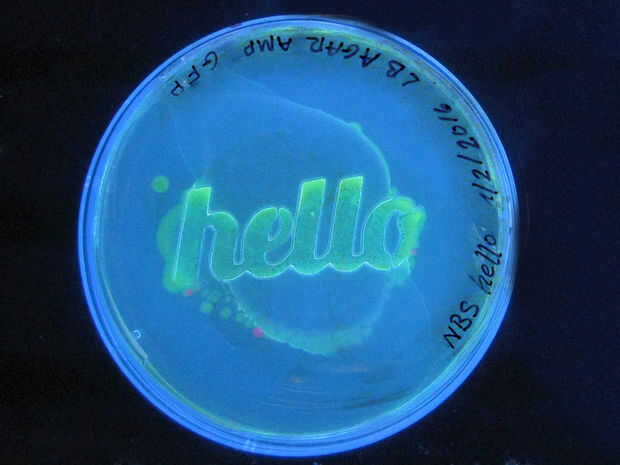

Piezas anteriores-Apuntando el foco en LinkIt unoIntroducción a LinkItOneFamiliarizarse con el IDE de Arduino: LinkItOneLos programas que escribimos para un LinkIt se denominan bocetos. Dentro el dibujo tenemos un mínimo de los dos métodos siguientes
¿Tenido anhelan crecer millones de algo? Con un hisopo pequeño desde el interior de la boca o el respaldo del asiento del inodoro, tendrás un imperio de granja bacterias verdadero en ningún momento a todos. ¿Siempre ha querido demostrar que la boca d
Hola a todos!!!!Espero que está teniendo un buen día y siga así. En mi segunda instructables, quisiera compartir un poco canapés que había aprendido en ubuntu. Me gustaría compartir sobre basic de programación paralela en ubuntu... Cualquier comentar
En este post vamos a aprender cómo conectar y configurar el dispositivo Android (Smartphone, etc.) con el estudio de Android. Después de se ejecute un simple Hola mundo programa. Sólo tienes que seguir siguientes pasos:Paso 1: Habilitar opción de Des
El Othermill es un molino de escritorio poco ingenioso que puede fabricar cosas sorprendentes a una variedad de mercancías. Tarjetas de circuitos impresos para electrónica son algo que maneja muy bien.Aquí hay un tutorial para un Consejo básico jugar
Hola otra vez amigos! Este es mi Instructable segundo y el primero en inglés! Pensé que podría ser buena a la gente escribir en inglés así que, aquí vamos!Al principio lo siento por mi mala Inglés, prometo mejorar practicando en mis tutoriales.Hace m
se trata de un "vivir INSTRUCTABLE" sobre un nuevo descubrimiento.CRECER, MADURAR Y MEJORAR ESPECTACULARMENTE CON EL TIEMPO. COMO SE GANA EXPERIENCIA Y CONOCIMIENTO, ACTUALIZARÉ MIS RESULTADOS AQUÍ EN PRIMER LUGAR, PROPORCIONAR UNA MANERA CON
¡ Hola gente! Aquí está mi Tutorial de "Hola mundo" para el Kinect Microsoft usando v1.8 SDKEn este tutorial utilizaremos Visual Studio (en mi caso 2015) para crear una aplicación de WPF el Kinect para que se ponga en funcionamiento y con el SDK
El Othermill es un molino CNC escritorio fácil de usar que puede fabricar cosas sorprendentes a una variedad de materiales, incluyendo madera y metal. Grabado de placas de circuito impreso (PCB) para la electrónica es una de las tareas que maneja esp
El Othermill es un molino CNC escritorio fácil de usar que puede fabricar cosas sorprendentes a una variedad de materiales, incluyendo madera y metal. También es ideal para creación de prototipos PCB para proyectos hobby o fabricación.En este tutoria
en este instructable voy estar demostrando cómo cultivar plantas pequeñas bajo el resplandor glorioso de luces. Woop!Paso 1: introducción Ante todo... Hola!Este es mi primer instructable (lector de largo plazo, "en realidad-post-anythinger", es
IntroducciónEste tutorial está dirigido a cualquier persona que no tiene experiencia en programación de aplicaciones para el sistema operativo Android, pero le gustaría. Es muy básico, e instalar los programas necesarios es más complicado que la apli
Este instructable fue creado en cumplimiento de la exigencia de proyecto de la Makecourse de la Universidad de South Florida (www.makecourse.com)Hola, mundo es un proyecto simple en torno usando la placa Arduino y unos componentes diferentes. La part
El parpadeo del LED es una manera probada de obtener su tabla de trabajo, pero es algo cansado, así. Ya que hemos estado suministrando el escudo proto con las compras de arándano pensé que sería una buena idea para hacer algo diferente con el proyect